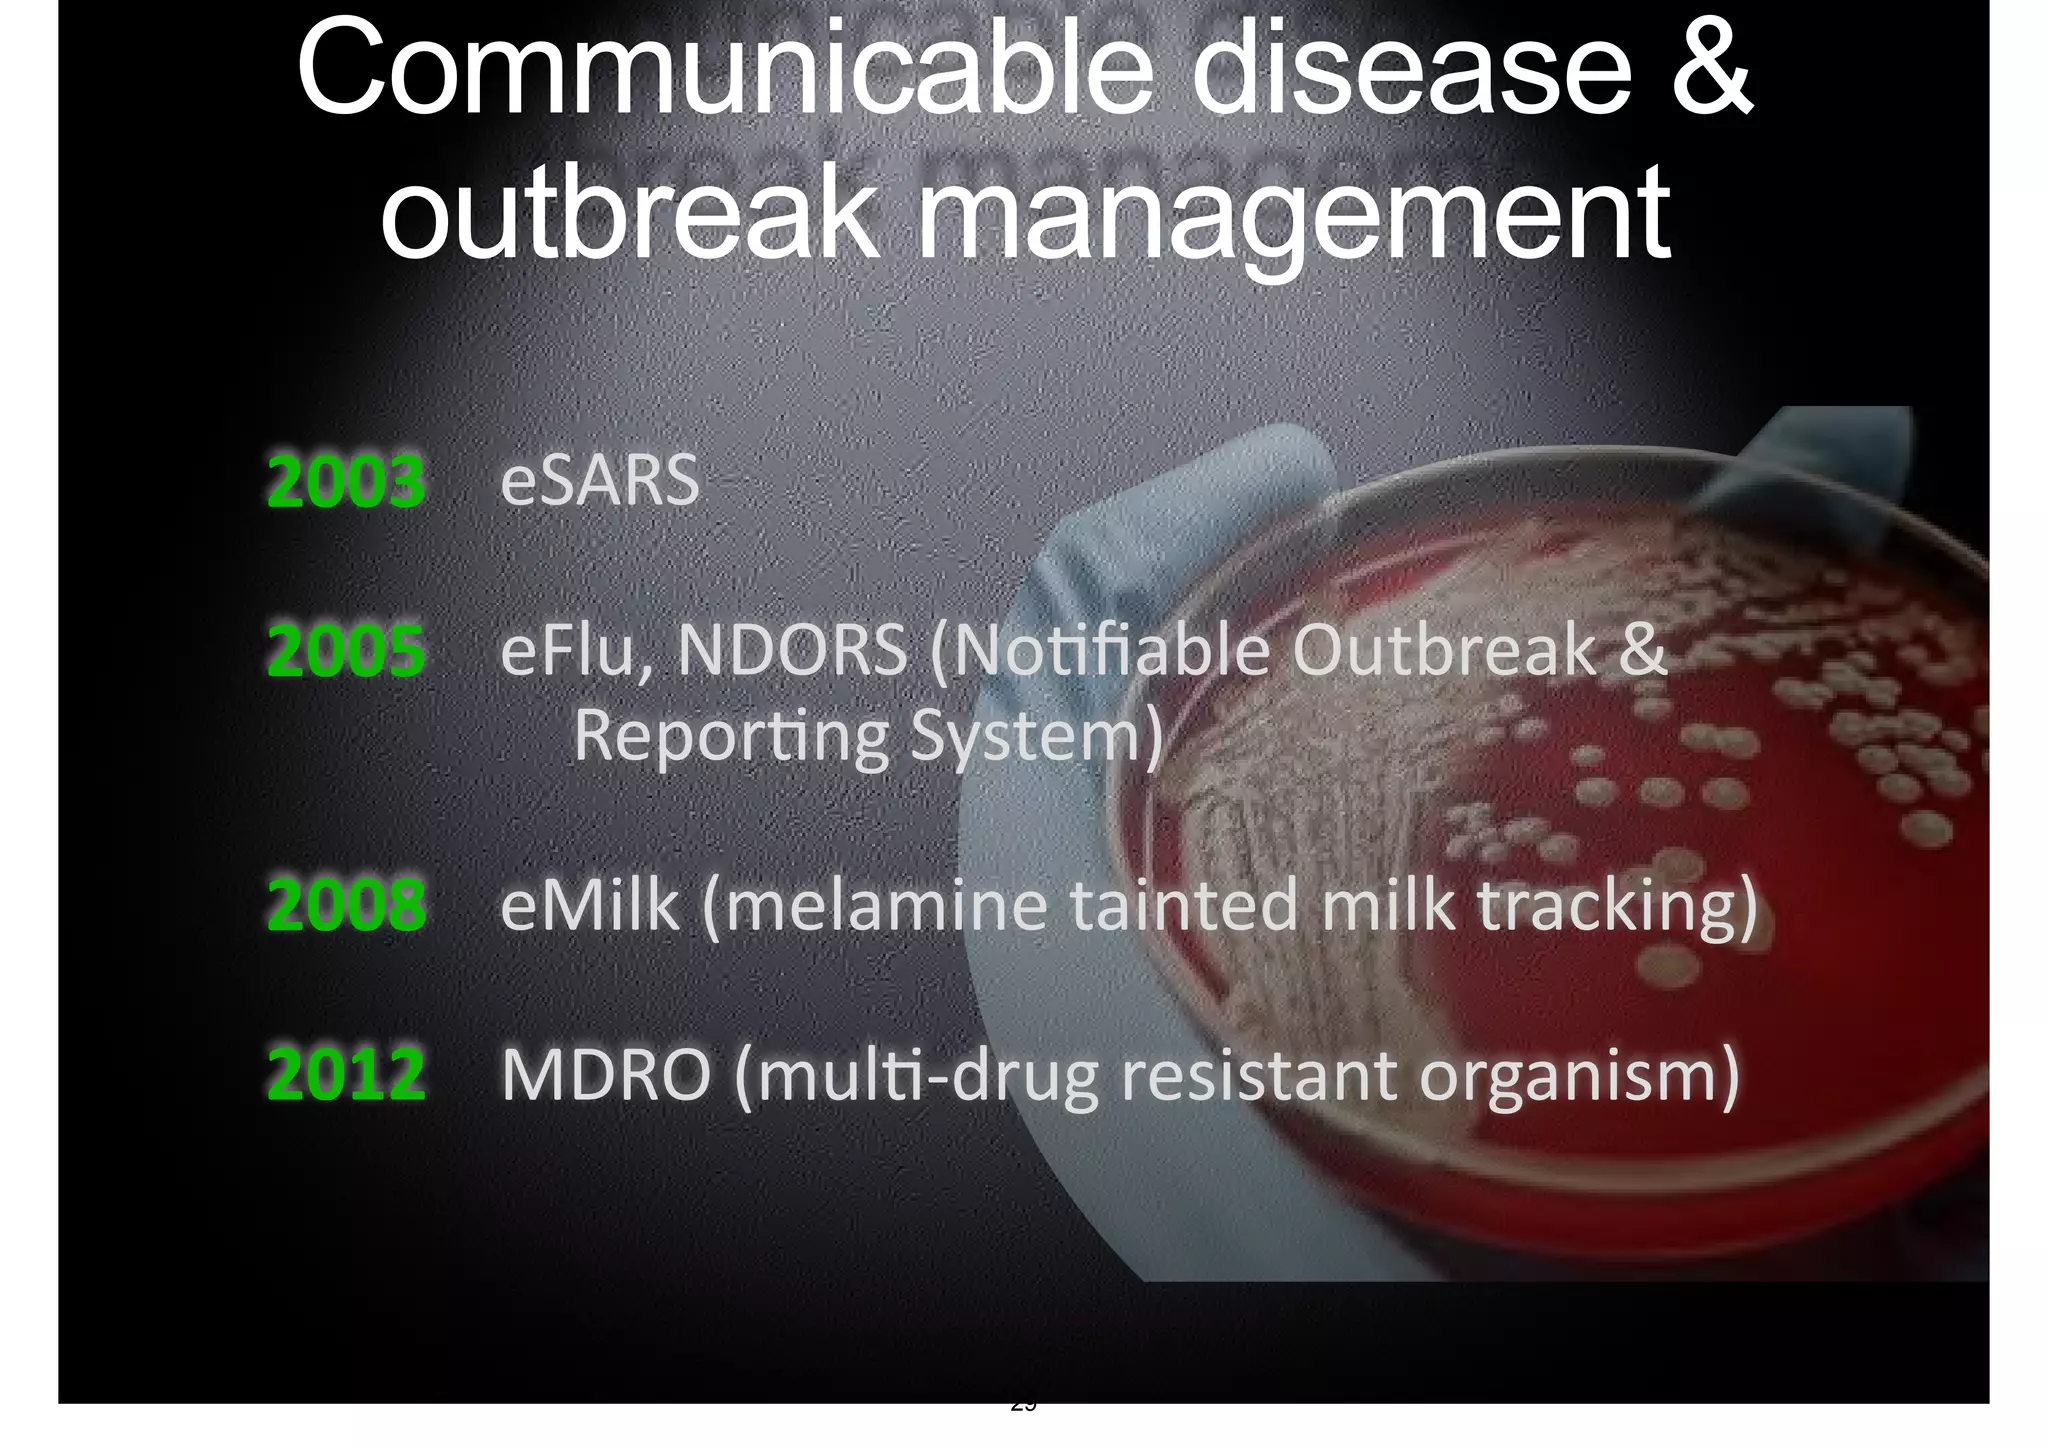
Communicable disease & 
outbreak management 
eSARS 
eFlu, NDORS (No-fiable Outbreak & 
Repor-ng System) 
eMilk (melamine tainted milk tracking) 
MDRO (mul--­‐drug resistant organism) 
2003 
2005 
2008 
2012 
29
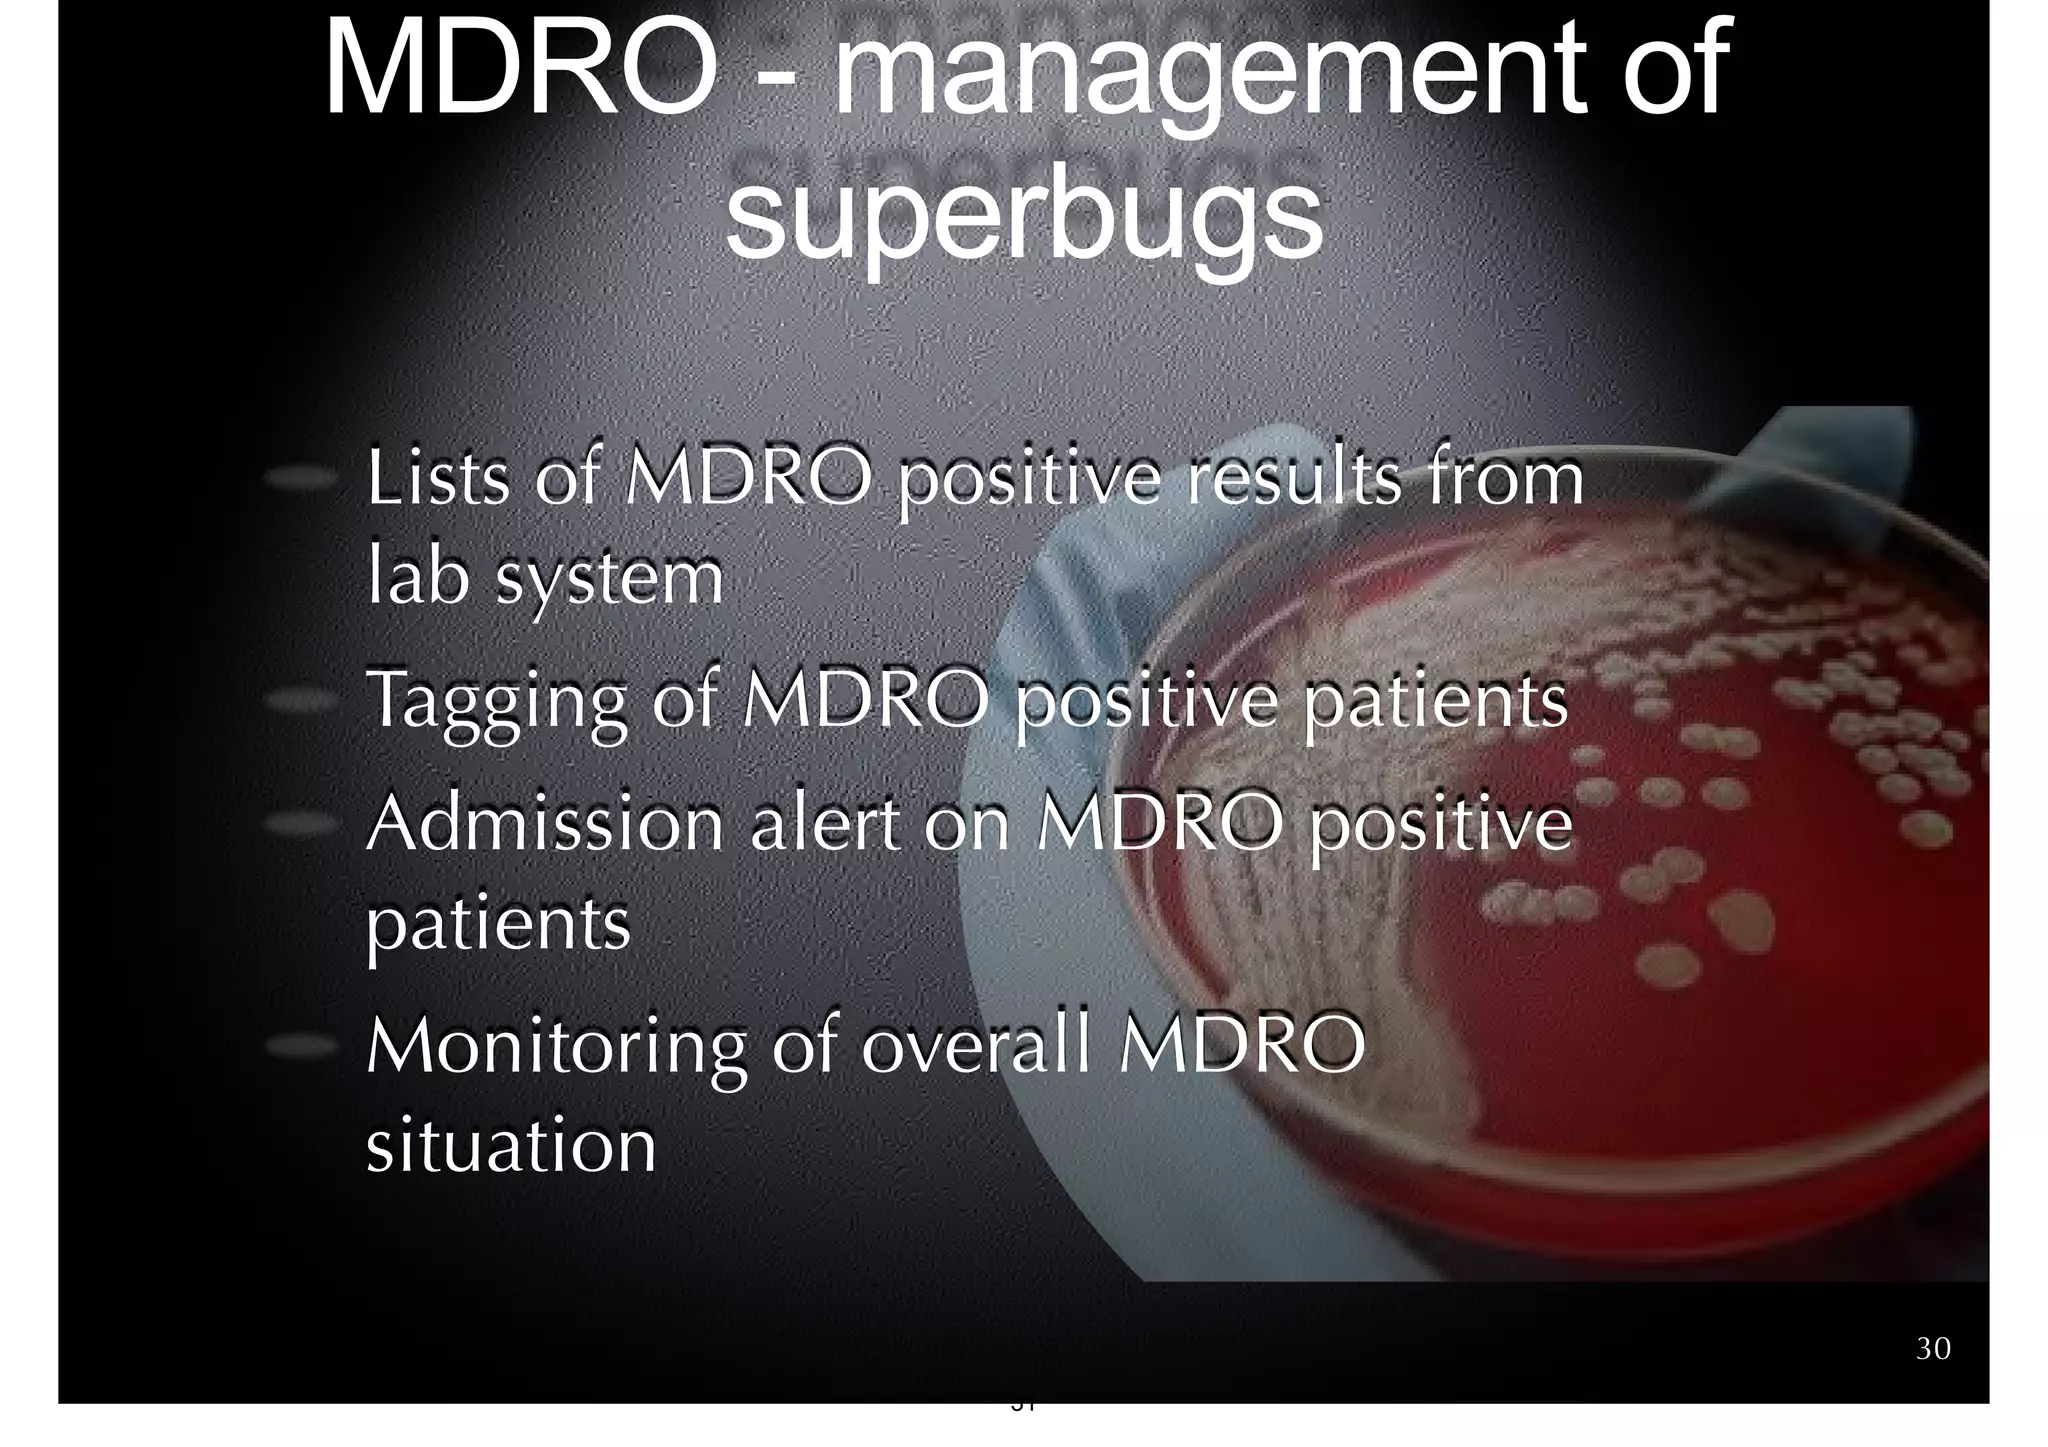
MDRO - management of 
superbugs 
Lists of MDRO positive results from 
lab system 
Tagging of MDRO positive patients 
Admission alert on MDRO positive 
patients 
Monitoring of overall MDRO 
situation 
30 
31

The document discusses the advancements in health informatics in Hong Kong, emphasizing the establishment of a standardized eHealth system aimed at improving healthcare delivery efficiency and safety. With a focus on data management and patient safety, the system has led to significant operational improvements and cost savings in healthcare services. It also highlights the ongoing development of integrated electronic health records and the impact of health informatics on chronic disease management and patient intake processes.